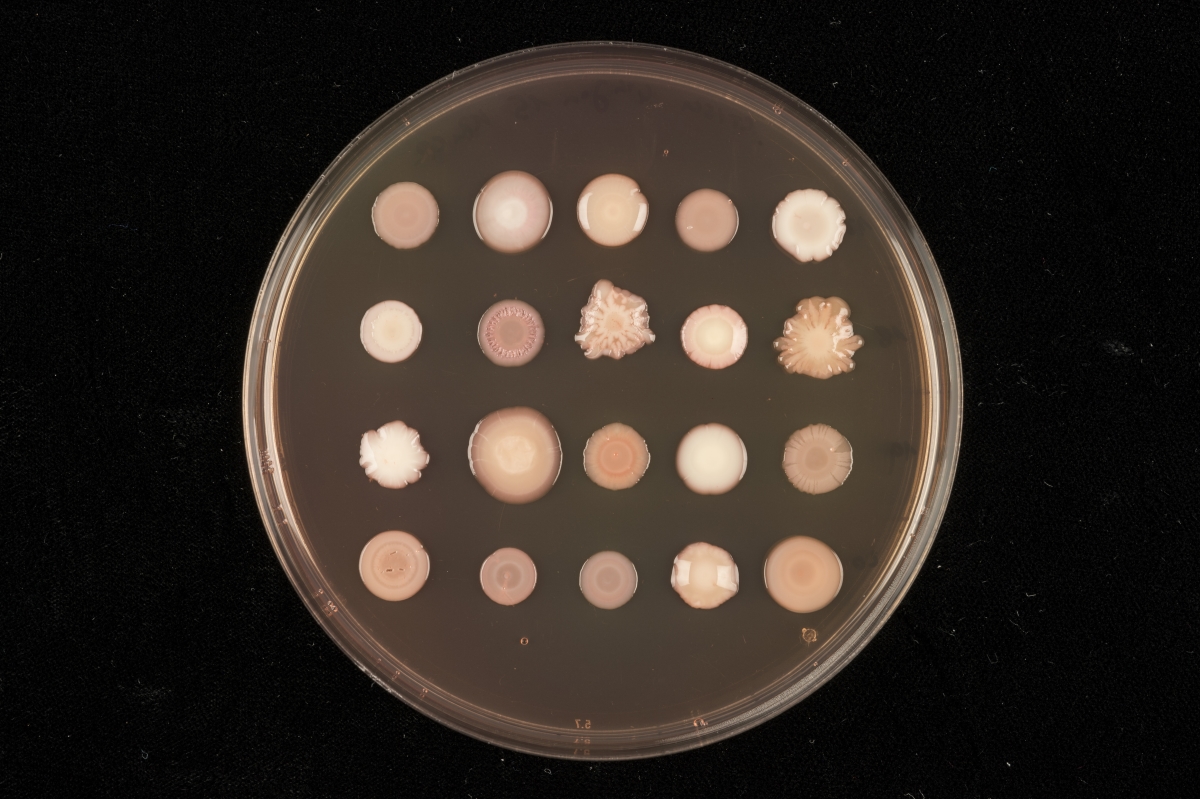

More News Stories
-
News Symbiotic partner-swapping or long-term fidelity? The secrets of partnership success between beetles and bacteria
Some insects and microbes develop symbiotic partnerships, which become so interdependent that they can no longer survive without each other. But how specific are these heritable symbioses? Is it possible for the same species of bacteria to flourish across different species of insect hosts, or are these partnerships more fixed, honed over millions of years of...
Read the story -
News Calling Norfolk teachers – apply for the SAW Trust’s ‘Curiosity Project’ today
Following successful funding applications to the Anguish’s Educational Foundation and the Norwich Freemen’s Charity, the SAW Trust is launching an exciting new project that seeks to boost curiosity in Primary schools through science! The Science, Art and Writing (SAW) Trust is a cross-disciplinary engagement initiative that explores scientific themes through practical science activities underpinned by...
Read the story -
News UK-CGIAR Centre brings together global expertise on gene editing regulation for food security
Policymakers and scientists from Egypt, Kenya, Morocco, Pakistan and the UK gathered in London for a mutual policy learning exercise on the regulation of biotechnology with potential to improve hunger and food security
Read the story